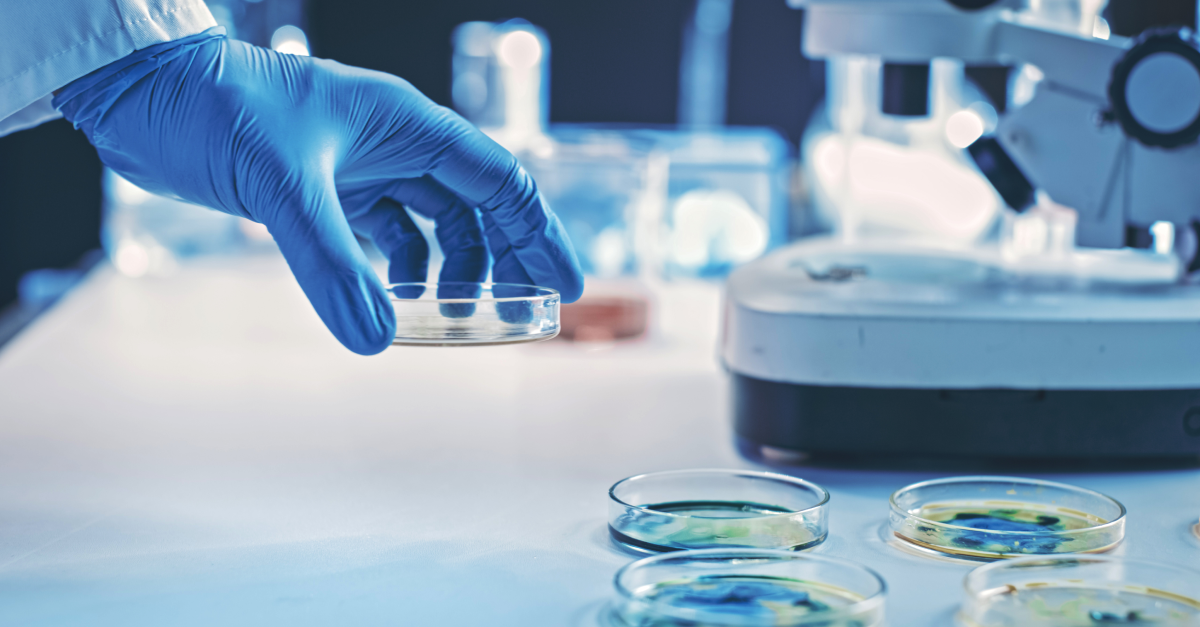
ecoa in clinical trials

Every clinical research organization aiming to uphold data integrity, accelerate trial timelines, and maintain regulatory compliance must focus on selecting the best clinical data management system (CDMS) for their needs. As studies become more complex and data sources more diverse, the need for a robust, scalable, and secure clinical data management solutions grows exponentially. Whether you’re launching a single-site study or managing a global, multi-phase trial, the best clinical data management system must support seamless data integration, enable real-time access to insights, and offer user-friendly tools for clinical trial data collection. Most importantly, it must safeguard data integrity in clinical trials, ensuring that every data point collected, validated, and reported can stand up to regulatory scrutiny.
Let’s jump in and learn:
Choosing the best clinical data management system is pivotal to ensuring the success of your clinical trial. An ideal CDMS goes beyond simple data capture. It becomes a centralized engine that powers your study’s accuracy, compliance, speed, and scalability. The right platform should seamlessly support your study’s evolving needs while maintaining data integrity in clinical trials and aligning with stringent regulatory requirements. Let’s explore the key features every sponsor, CRO, and research site must evaluate before investing in a CDMS.
At the heart of every successful CDMS is an intuitive user interface. Clinical data teams include everybody from data mangers to site coordinators. Every team and individual must be able to navigate the system without the need for excessive training or technical support. A steep learning curve can slow down trial initiation, increase operational errors, and impact compliance.
The best clinical data management system offers:
System flexibility is equally critical. As your study grows, the CDMS should allow seamless adaptations, including adding new data fields, modifying visit structures, and integrating remote monitoring. These adaptations should not cause downtime or data migration hassles.
Efficient clinical trial data collection begins with a well-designed eCRF engine. The eCRF is the cornerstone of data entry and must be both robust and adaptable.
While evaluating CDMS solutions, ensure the platform provides:
The best clinical data management system allows for easy mid-study updates to eCRFs without interrupting existing data flows. This is a crucial capability in adaptive trial designs and post-marketing surveillance studies.
In today’s digital trial environment, integrating data from multiple sources is non-negotiable. From wearables and EHRs to imaging systems and laboratory information systems, a modern CDMS must function as a central hub.
Look for seamless data integration capabilities that support:
By supporting seamless integration, the best clinical data management system ensures that you get a holistic, real-time view of patient progress and study metrics, all without manual intervention.
Compliance is foundational in clinical research. Regulatory bodies such as the FDA, EMA, and MHRA mandate strict adherence to data integrity, auditability, and participant confidentiality standards.
A reliable CDMS should support:
In short, the best clinical data management system stores your data, protects your study from regulatory pitfalls, and ensures long-term credibility.
Timely decision-making in clinical trials hinges on immediate access to high-quality data. Real-time visibility into subject status, protocol deviations, and adverse events empowers sponsors to intervene early and keep the trial on track.
Key capabilities include:
These tools are especially vital for risk-based monitoring (RBM) strategies, where continuous oversight replaces traditional on-site audits. The best clinical data management system empowers sponsors and CROs with this level of real-time control.
Data quality is the bedrock of credible study results. A high-performing CDMS must support comprehensive query management tools that streamline communication between data managers and site staff.
Features to look for include:
Additionally, customizable logic checks can detect protocol deviations, outliers, or incomplete data in real time. When implemented effectively, these capabilities contribute directly to data integrity in clinical trials, enhancing submission-readiness and audit success rates.
Clinical trials rarely stay static. You may expand to new sites, introduce new cohorts, or extend timelines. The best clinical data management system should support this evolution without sacrificing performance or security.
Scalability considerations include:
A scalable CDMS ensures your system grows with your organization without requiring frequent migrations, costly upgrades, or prolonged revalidations.
Finally, insight drives impact. A forward-looking CDMS should offer built-in reporting and analytics tools to empower data-driven decision-making.
Essential tools include:
These features do more than simplify operations. They provide sponsors with the evidence needed to support trial extensions, regulatory interactions, or investment decisions. The best clinical data management system is, therefore, not just a data repository but an intelligence engine.
Evaluating a CDMS is about more than simply ticking off features. It’s about ensuring alignment with your study’s goals, compliance needs, and future roadmap. From intuitive design and seamless data integration to robust compliance and real-time monitoring, these features collectively define what makes a CDMS platform the best clinical data management system for your study. When chosen wisely, your CDMS will help manage your data, empower your team, optimize your times, and uphold the highest standards of clinical excellence.
A well-chosen CDMS can streamline clinical trial data collection, enhance data integrity in clinical trials, and provide a solid foundation for scalability and compliance. Conversely, a poorly matched system can lead to inefficiencies, delays, and regulatory setbacks. Follow these best practices to make an informed and confident selection.
Before evaluating any CDMS solution, it’s essential to align your internal teams on what your clinical trial truly needs. This includes understanding:
Creating a comprehensive requirements document will help you assess potential platforms more objectively. The best clinical data management system will meet your current study requirements and offer the flexibility to scale or adapt as your trial design evolves.
Technology alone doesn’t guarantee success. A CDMS provider’s domain expertise and support infrastructure can make or break your clinical operations. Consider the following when assessing a vendor:
The best clinical data management system is backed by a partner who understands the nuances of clinical research and provides proactive, responsive support throughout the study lifecycle.
No matter how promising a CDMS appears on paper, it’s critical to validate its performance through pilot testing and user acceptance testing (UAT). This hands-on trial phase can surface potential usability issues, technical gaps, or workflow mismatches before full-scale implementation.
Effective pilot testing should evaluate:
Gathering structured feedback from users during this phase ensures you adopt the best clinical data management system for your functional requirements and everyday use.
While initial costs often dominate procurement discussions, smart teams focus on total cost of ownership (TCO) and return on investment (ROI). Evaluate how the CDMS contributes to both operational efficiency and strategic value over time.
Consider:
The best clinical data management system is a value multiplier across clinical operations, regulatory strategy, and portfolio management.
Regulatory scrutiny and data breaches are constant risks in clinical research. Your CDMS must offer enterprise-grade security and be fully compliant with global regulations to protect patient data and ensure audit-readiness.
Ensure your shortlisted system adheres to:
The best clinical data management system embeds these safeguards into its core architecture, ensuring that every stakeholder can operate with confidence.
Centralized and Secure Data Management
Regulatory Compliance and Audit Readiness
Streamlined Workflows and Automation
Enhanced Collaboration and Real-Time Monitoring
Data Integrity and Quality Assurance
Flexible Integration and Scalable Architecture
Key Solution Components
Egnyte’s best clinical data management system helps sponsors, CROs, and research teams improve speed and efficiency, strengthen regulatory posture, maintain high data quality, and enhance cross-functional collaboration.
MOMA Therapeutics, a precision medicine biotech based in Cambridge, MA, relied on outsourced CRO partnerships and experimented with lab instruments that generated critical R&D data. They struggled to ensure secure, efficient data exchange without relying on email or thumb drives. By deploying Egnyte’s cloud-based clinical trial management system, MOMA seamlessly connected 16 lab instruments directly to Egnyte, enabling CRO scientists to simply drop assay data into designated folders and have immediate access onsite. The solution offered granular, role-based access controls, comprehensive audit trails, and real-time alerts, making it easy to audit the entire content lifecycle and ensuring compliance with PHI/PII regulations. Egnyte’s platform turned a previously fragmented, insecure process into a unified, secure, and investigator-ready CDMS with zero additional administrators and fast, intuitive onboarding for lab teams and external partners.
In today’s fast-paced, data-driven clinical research landscape, selecting the best clinical data management system ensures seamless data integration, life sciences regulatory compliance, real-time monitoring, and data integrity across every stage of your study. As trials grow in complexity, the right solution must do more than collect data. It must simplify workflows, enhance collaboration, and scale effortlessly with your operations. From automated validation to AI-powered insights, your CDMS should empower your teams to make faster, smarter, and more compliant decisions. Egnyte’s clinical data solutions are purpose-built to meet the evolving needs of sponsors, CROs, and research teams. With centralized, secure document control, real-time collaboration, and a flexible, audit-ready architecture, Egnyte helps life sciences organizations accelerate their path from discovery to approval while safeguarding data and ensuring regulatory excellence. Whether you’re planning your first trial or expanding your portfolio, now is the time to invest in a solution that delivers long-term value and operational clarity. Choose the best clinical data management system to unlock the full potential of your clinical research.
A: The primary difference between cloud-based and on-premise Clinical Data Management Systems (CDMS) lies in their deployment, scalability, and IT requirements.
Cloud-based CDMS platforms are hosted on remote servers and accessed via the internet, offering high availability, automated updates, and easy scalability. These systems minimize the need for in-house IT infrastructure and allow remote access for distributed teams, making real-time data sharing and collaboration seamless. For organizations seeking flexibility, rapid implementation, and cost efficiency, cloud-based platforms are often the best clinical data management system choice.
On the other hand, on-premise CDMS solutions are installed on local servers and managed internally. While they offer full control over data and compliance protocols, they typically involve higher upfront costs, longer deployment times, and increased maintenance overhead. This makes them better suited for organizations with strict data residency requirements and established IT infrastructure.
A: Implementation timelines vary depending on the system type, trial complexity, and customization needs. Generally, cloud-based CDMS solutions can be deployed in a matter of days to a few weeks, thanks to their pre-configured modules and minimal hardware requirements. These platforms also allow parallel setup of integrations, training, and user onboarding, accelerating go-live timelines.
Conversely, on-premise systems often require several weeks to months for full deployment due to hardware setup, manual installation, and IT configuration. Regardless of the system, the implementation process may also include data migration, user role setup, validation, and compliance checks, all of which influence the total deployment time.
A: An efficient CDMS can significantly lower clinical trial costs by driving operational excellence and minimizing inefficiencies. Let’s better understand how it helps.
With these advantages, CDMS solutions enhance trial performance and serve as a strategic tool for cost-effective clinical trial management.
A: A CDMS plays a vital role in facilitating accurate and timely adverse event reporting, which is a critical component of patient safety and regulatory compliance.
By enhancing data accuracy, accelerating timelines, and supporting global compliance standards, a well-designed CDMS significantly improves the quality and reliability of adverse event management in clinical trials.
Egnyte has experts ready to answer your questions. For more than a decade, Egnyte has helped more than 22,000+ customers with millions of users worldwide.
eCOA digitizes clinical outcome assessments to boost data accuracy, reduce errors, enhance patient engagement, and ensure ...

Egnyte eTMF streamlines milestone tracking—activate, manage, and monitor 12 clinical trial milestones with automated dates and ...

Discover how Vial uses Egnyte’s cloud technology to streamline data management, enhance security, and run ...